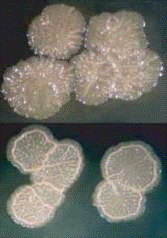
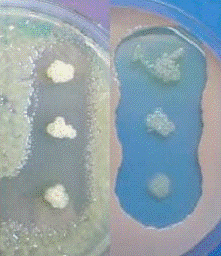

Физиолого-биохимическая характеристика вида Pseudomonas corrugata
ФИЗИОЛОГО-БИОХИМИЧЕСКАЯ
ХАРАКТЕРИСТИКА
ВИДА PSEUDOMONAS CORRUGATA
Оглавление
Введение
1. Обзор литературы
1.1 Характеристика вида
1.2 Внутривидовая гетерогенность
1.2.1 Серологическая гетерогенность
1.2.2 Выделение Ps. mediterranea
1.3 Некротические поражения сердцевины стебля томата, их
характеристика
1.4 Антагонизм по отношению к другим микроорганизмам
1.4.1 Биологически активные соединения
2. Материалы и методы
2.1 Объекты исследования
2.2 Среды и растворы
2.3 Методы исследования
3. Результаты исследований и их обсуждение
Выводы
Список литературы
Введение
Pseudomonas corrugata - опасный фитопатоген,
прежде всего томата. Вызываемые им заболевания наносят серьёзный ущерб
сельскому хозяйству. Встречается по всему миру. Распространённости патогена
способствует способность сохраняться в почве и воде. Диагностику затрудняет
высокая внутривидовая гетерогенность и, как следствие, неприменимость
серологического анализа. Важным инструментом видового определения является ПЦР
анализ.
В данной работе предпринята попытка применить ПЦР-анализ к
выделенным из заражённых растений и коллекционных штаммам, ранее отнесённым к Ps. Сorrugata на основе определения
нуклеотидной последовательности генов рибосомальной РНК.
1.
Обзор литературы
1.1
Характеристика вида
Pseudomonas corrugata впервые описаны в 1978
как фитопатоген, ответственный за некроз сердцевины томата в Великобритании.
Систематическое положение: царство Bacteria; группа Proteobacteria,
γ-секция; порядок Pseudomonadales; семейство Pseudomonadaceae;
род Pseudomonas. Сообщения о выделении поступали из множества
государств, включая США, Канаду, страны Европы, Южную Африку, Новую Зеландию,
Израиль, Китай и Россию. Также идентифицируется в качестве возбудителя некроза
сердцевины перца, стеблевой гнили хризантем и некроза сердцевины герани.
Бактерии встречаются повсеместно, выделяются из почвы и воды, а также в
отсутствие симптомов заболевания из ризосферы пшеницы, корней люцерны и
различных частей других растений (табл.1) (Catara et al., 2002; Guo et al., 2007).
Таблица 1
Источники выделения Ps. corrugata, не проявляющие
симптомов заболеваний (Catara, 2007)
|
Источник
|
Локализация
|
Упоминание
|
|
тысячелистник
|
корни
|
Picard and Bosco (2003)
|
|
брокколи
|
кочан
|
Pagada
et al. (2000)
|
|
рапс-канола
|
кончики корней
|
Fernando
et al. (2005)
|
|
огурец
|
ризосфера
|
Paulitz
et al. (1992)
|
|
виноград
|
листья
|
Bell
et al. (1995)
|
|
люцерна
|
корни/листья
|
Lukezic
(1979)
|
|
фасоль
золотистая
|
проростки
|
Bennik
et al. (1998)
|
|
картофель
|
клубни
|
Garbeva
et al. (2001)
|
|
дуб черешчатый
|
кончики микоризных
корней
|
Sbrana
et al. (2002)
|
|
рис
|
зёрна
|
Cottyn
et al. (1996)
|
|
земляника
|
усы
|
Tanprasert
and Reed (1997)
|
|
чай
|
ризосфера
|
Pandey
et al. (2000)
|
|
трюфель
беловатый
|
спорокарп
|
Bedini
et al. (1999)
|
|
пшеница
|
ризосфера
|
Бактерии Ps. corrugata представляют собой
неспороносные подвижные (полярное жгутикование) клетки. Грамотрицательны. На
картофельном агаре образуют кремово-коричневые колонии, проявляющие
специфический рост: их поверхность складчатая, а края неровные, морщинистые (с
этим и связывают видовое название: "corrugata" означает
"морщинистый") (рис.1). Иногда в центре колоний отмечают зелёную
окраску. На пептонном агаре с добавлением глюкозы (УДС) бактерии образуют
голубой, диффундирующий в среду пигмент. На среде Кинга Б не производят
флюоресцирующий пигмент. На глюкозо-дрожжевом агаре колонии плоские
желтовато-зелёного цвета и также с неровной поверхностью. Бактерии выделяют в
среду желтовато-зелёный нефлюорисцирующий пигмент. Оптимальная температура для
роста колоний 26-28ºC. Рост колоний
прекращается при температуре более 41ºC. Бактерии
характеризуются относительно быстрым развитием на питательных средах: так, на
картофельном и пептонном агаре на 4-5 сутки роста колонии достигают размера
2,4-3 и 3,5-4 мм соответственно.
Рисунок 1. Колонии Ps. Corrugate на питательной среде
содержащей глюкозу (Catara, 2007).
Разжижают желатин (не все штаммы), не гидролизуют крахмал и
L-аргинин, не образуют леван, оксидазо- и лецитиназоположительные. Продуцируют
кислоту из галактозы, ксилозы, маннозы, мелибиозы, рибозы, трегалозы, сахарозы,
фруктозы, глицерина, инозита, маннита, но не утилизируют лактозу, мальтозу,
раффинозу, рамнозу, сорбозу, сорбит, инулит, эритрин, адонит, декстрин,
дульцит, целлобиозу. Патоген усваивает из аминокислот и аминов - аргинин,
аспарагин, глютамин, гистидин. Не усваивает из солей органических кислот -
глюконат. Отмечается вариабельность в отношении ацетата, цитрата, формиата,
фумарата, гиппурата, лактата, малата, оксалата, пропионата. Бактерии растут при
температуре 37ºC, рост отсутствует при 41ºC (Прищепа, Вабищев, 2008).
Ps. corrugata не продуцирует флюорисцирующих пигментов,
однако на основе анализа нуклеотидных последовательностей генов 16s РНК
относится к группе флюорисцирующих псевдомонад (группа Ps. fluorescens) (Anzai, et al., 2000).
Полное определение нуклеотидной последовательности генома Ps. corrugata на данный момент не
произведён (Catara, 2007).
.2
Внутривидовая гетерогенность
1.2.1
Серологическая гетерогенность
Эксперименты со 128 штаммами из различных стран показали
высокую серологическую гетерогенность вида. Против типового и двух выделенных в
Испании из томата и перца штаммов были получены три типа антител.83 штамма
прореагировали с одним, 6 с двумя и ни один со всеми тремя.39 изолятов не
прореагировали ни с одним. Это делает антигенный анализ малопригодным для
диагностики Ps. corrugata, пока не будут выделены специализированные
антитела. Высокую гетерогенность связывают с большим количеством типов
липополисахаридов мембран (более 10). Корелляций между географическим
положением источника или поражаемым организмом и липополисахаридной группой не
выявлено. Более того, принадлежащие к одной группе штаммы выделялись из разных
растений одной теплицы (Siverio et al., 1993).
1.2.2
Выделение Ps. mediterranea
На основе семи биохимических тестов вид был разделён на
группы и подгруппы (табл.2). Группа 1 отличается от групп 2 и 3 способностью
утилизировать 2кето-D-глюконат, мезо-тартарат, гистамин и DL-глицерат. Группы 2
и 3 разделяют по способности вызывать реакцию гиперчувствительности у табака (Catara et al., 1997).
Таблица 2
Гетерогенность штаммов (Catara et al., 1997)
|
Биохимический
тест
|
Группы и
подгруппы
|
|
1
|
1А
|
1В
|
2
|
3
|
3А
|
3В
|
3С
|
|
утилизация
2кето-D-глюконата
|
+
|
+
|
+
|
-
|
-
|
-
|
-
|
-
|
|
утилизация
мезо-тартарата
|
+
|
+
|
+
|
-
|
-
|
-
|
-
|
-
|
|
утилизация
гистамина
|
+
|
+
|
+
|
-
|
-
|
-
|
-
|
-
|
|
утилизация DL-глицерата
|
+
|
+
|
+
|
-
|
+/-
|
+
|
-
|
+/-
|
|
гидролиз
желатина
|
+/-
|
-
|
+
|
-
|
+/-
|
+
|
+
|
-
|
|
реакция
гиперчувствительности табака
|
+/-
|
+/-
|
+
|
+
|
-
|
-
|
-
|
Примечание: +/ - 10-89% штаммов положительны
В дальнейшем вид был организован в более крупные ветви А,
включающую группы 2 и 3, и В, включающую штаммы группы 1 (соответственно 1a и
1b подгруппы псевдомонад по Sutra et al., 1997). При амплификации с
видоспецифичными праймерами PC5/1-PC5/2 и PC1/1-PC1/2 (последовательности
праймеров случайны, подобраны методом RAPD ПЦР и к функциональным генам не приурочены) были
получены различные продукты: 1100 п. о. для группы А (I) и 600 п. о. для группы
В (II). (Catara et al., 2000) На основе этих данных штаммы группы В выделены в
отдельный вид Ps. mediterranea. Данный вид встречается преимущественно в
странах Средиземноморья: Италии, Испании, Франции. (Catara et al., 2002) В 2005 поступили
сообщения о выделении Ps. mediterranea из помидоров, поражённых
некрозом сердцевины, в Турции и Португалии. При диагностике применялся ПЦР
анализ (Basil et al., 2005; Moura et al., 2005).
1.3
Некротические поражения сердцевины стебля томата, их характеристика
Ps. сorrugate вызывает некроз сердцевины
стебля (пустостебельность) томата (Lycopersicon esculentum), или бурый некроз
сердцевины стебля.
Появление этого заболевания и его интенсивность меняются из
года в год. Оно обнаружено во многих странах Европы, в Северной Америке и
Австралии. В настоящее время этот бактериоз является достаточно
распространённой и вредоносной болезнью томата выращиваемого в теплицах без
обогрева или обогреваемых только в начале сезона.
Снижение урожая в результате преждевременной гибели растений
может составлять 50-80%. Размер потерь в производственных условиях зависит от
срока появления болезни и факторов внешней среды. Наиболее интенсивно это
явление наблюдается в самом начале плодоношения. Большие потери урожая возможны
при раннем заражении через семена. В этом случае погибает значительная часть
растений. В настоящее время отсутствуют устойчивые сорта и гибриды томата к
возбудителю заболевания.
Заболевание особенно сильно поражает мощные растения, с
хорошо развитой корневой системой. Пораженные растения всегда очень жизнеспособны,
имеют толстые мясистые стебли и крупные листья, хотя часто рост корней
блокируется, и они начинают походить на концах на горлышко бутылки.
Первоначальные признаки бактериоза наблюдают во время плодоношения (образование
второй-третьей кисти): в центральной части долей листа (между жилками) отмечают
светлые округло-продолговатые пятна, которые постепенно увеличиваются в
размерах, а дольки листа скручиваются кверху (эти симптомы особенно заметны в
солнечные дни), рост в это время несколько задерживается. В некоторых случаях
фиксируют некроз верхушки центральной доли листьев, который распространяется
"языком" вдоль центральной жилки. Пораженные листья имеют вид
"обваренных", хотя сохраняют зелёный цвет и у них видны тёмно-зелёные
маслянистые жилки.
На поверхности больных стеблей наблюдают небольшие пятна
продолговатой формы, располагающиеся преимущественно выше уровня почвы на 25-30
см. Позднее (в большинстве случаев) на больных стеблях развиваются
некротические полосы тёмно зелёной окраски и длиной 25-50 см, что служит одним
из основных симптомов данного бактериоза. При этом возможна сильная мацерация
поражённых тканей с разрушением сердцевины, из которой на поперечном разрезе
легко можно выдавить слизистый экссудат (белой или кремовой окраски). Из рубцов
на стебле, остающихся от листьев, также может выделяться бактериальная слизь.
На более позднем этапе развития заболевания на стеблях отмечают трещины с
пустотами внутри и побуревшей сердцевинной тканью. При микроскопировании такой
ткани наблюдают приплюснутые (бесформенные) клетки бурого цвета, в которых
видны подвижные бактерии.
На стеблях (как в прикорневой части, так и по всей их длине)
формируются адвентивные корни (длиной до 3-7см), меняющих окраску от белой до
ржаво-коричневой. Сначала появляется множество мелких изолированных или
выровненных бугорков, которые затем растрескиваются, давая возможность расти
корням.
В местах образования адвентивных корней внутренняя часть
стебля полая: создаётся впечатление, что растение тратит содержимое стеблей на
их отрастание. Корневая система таких растений обычно не имеет повреждений.
У зрелых плодов, взятых от больных растений, вокруг
цветоножки могут просматриваться двойные кольца, тёмно-коричневые в центре и
светло-коричневые по периферии. Иногда от внешнего кольца отходят короткие (4-6
мм) лучи, в зоне которых возникают трещины. В ряде случаев на плодах отмечают
характерные "сетки" светло-серых жилок (характерно для зелёных
плодов). Встряхивание растений приводит к опадению плодов.
На симптоматику заболевания оказывают большое влияние условия
внешней среды и физиологическое состояние растений. Течение инфекционного
процесса бактериоза усиливает высокая температура, которая, как правило,
значительно повышается в условиях теплицы в дневное время (с 11 до 15 часов). В
этом случае нередко фиксируют быструю гибель растений. Интенсивному проявлению
болезни способствуют также перепады дневной и ночной температур, в результате
чего образуется конденсационная влага на растениях, а также внесение избыточных
норм азотных удобрений. Если для развития болезни складываются неблагоприятные
условия, то слабо поражённые растения (с незначительными изменениями сердцевины
стебля) могут завершить вегетацию и дать небольшой урожай плодов.
В ряде случаев фиксируют совместное поражение томата некрозом
сердцевины стебля и бактериального рака, что значительно ускоряет гибель
растений. При визуальной диагностике и сравнении внешних признаков этих
бактериозов используют срез поражённого растения: при некрозе сердцевины стебля
наблюдают некроз ткани, при бактериальном раке - потемнение сосудов с
выделением бактериальной слизи. Инкубационный период заболевания составляет не
менее 18 дней. Инфекция сохраняется на растительных остатках до 5 месяцев
(Прищепа, Вабищевич, 2008).

Рисунок 2. Поражённый стебель (photoshelter.com).

Рисунок 3. Поражённые стебель и плод (erec. ifas. ufl.edu).

Рисунок 4. Поражённые плоды (hort. cornell.edu).
pseudomonas corrugata фитопатоген томат

Рисунок 5. Придаточные корни на стебле (hort. cornell.edu).

Рисунок 6. Хлороз и увядание листьев (hort. cornell.edu).
Резервуаром инфекции служит почва и ризосферы растений (не
только поражаемых). Бактерии сохраняются в песчаных суглинках лучше, чем в
песчаных почвах. В пустой почве численность бактерий за 10 недель падает (хотя
их всё ещё можно выделить), по сравнению с почвой, в которую были высажены
томаты, где численность сохраняется постоянной (Bella et al., 2003). Также
распространяется с семенами и водой, что позволяет заболеванию распространяться
в безгрунтовых агросистемах.
Возбудители проникают в ткани растения через повреждения
стебля и корней. Бактерии, в первую очередь, колонизируют паренхиму. По мере
развития заболевания поражается ксилема и эпидермис, в виде жидких бактериальных
выделений.
Бактерии адгезируются на клеточных стенках растения с помощью
экзополисахаридов - альгиновых кислот, представляющих собой ацетилированные
полимеры маннуроновой кислоты с очень низким содержанием мономеров гулуроновой
кислоты (рис.7) (Fett et al., 1996).

Рисунок 7. Экзополисахаридный матрикс. A - отдельные клетки, 4
часа после заражения; В - волокнистое межклеточное вещество, 12 часов; С -
клетки в экзополисахаридном матриксе, 24 часа; D - 96 часов (Catara, 2007).
Бактерии имеют N-ацилгомосеринлактоновую систему quorum sensing, как фактор
вирулентности (Grazia et al., 2007).
В целом молекулярные и генетические аспекты вирулентности и
патогенности малоизученны.
1.4
Антагонизм по отношению к другим микроорганизмам
Ps. corrugata рассматривается как потенциальный агент
биологического контроля заболеваний. Сообщалось об антогонизме против оомицетов
рода Pythium, возбудителей мягкой гнили семян томата, при проращивании в
минеральной вате (Gravel et al., 2005), и саженцев кукурузы. (Pandey et al., 2001) При исследовании
методов биоконтроля Botrytis cinerea, возбудителя серой гнили томатов,
был выявлен широкий спектр антифунгальной и антибактериальной активности
непатогенного штамма P94.
Таблица 3
Фунгицидные свойства штамма P94 (Guo et al., 2007)
|
Фитопатогенный
гриб
|
Относительный
рост (%), по сравнению с культурой, инкубировавшейся без контакта с Р94
|
|
4 дня
|
6 дней
|
|
Botrytis
cinerea
|
65
|
40
|
|
Ceratocystis
fimbriata
|
51
|
32
|
|
Monilinia
laxa
|
53
|
35
|
|
Magnaporthe
grisea
|
64
|
57
|
|
Pythium
aphanidermatum
|
77
|
57
|
|
Phytophthora
capsici
|
68
|
60
|
|
Alternaria
solani
|
-
|
-
|
|
Rhizoctonia
cerealis
|
-
|
-
|
|
Fusarium
oxysporum
|
-
|
-
|
Таблица 4
Антибактериальная активность штамма P94 (Guo et al., 2007)
Зона подавления
роста (мм)
|
|
Pseudomonas corrugata ICMP 5819
|
23
|
|
Ps. syringae
|
25
|
|
Acidovorax avenae
|
28
|
|
Ralstonia
solanacearum
|
22
|
|
Xanthomonas
oryzae
|
-
|
|
X.
campestris
|
-
|
|
Agrobacterium
tumefaciens
|
-
|
|
A.
rhizogenes
|
-
|
|
A.
vitis
|
-
|
Антипатогенную активность связывают с выделением ферментов:
протеаз, целлюлаз, хитиназ, и антибиотиков (Guo et al., 2007).
Рисунок 8. Подавление роста Xanthomonas campestris pv. campestris и Rhodotorula pilimanae (Catara, 2007).
1.4.1 Биологически активные соединения
Кормицин А.
Данное вещество является липодепсипептидом: состоит из
замкнутой в кольцо пептидной части и остатков 3,4-дигидроксиизодекановой
кислоты (рис. и9). Вызывает лизис клеток бактерий, животных и растений. В
экспериментах проявлял активность против Bacillus megaterium и Rhodotorula
pilimanae. При инъекции в лист табака вызывал некротические повреждения за
24 часа. Также вызывает лизис эритроцитов. Механизм действия основан на
встраивании в мембраны, образовании пор и резком повышении пропускной
способности мембран. Ведутся исследования, направленные на получение фунгицидов
на основе кормицина (Scaloni et al., 2004).

Рисунок 9. Структурная формула кормицина А (Scaloni et al., 2004).
Корпептины А и Б.
Также липодепсипептиды, кислотная часть представлена
3-гидроксидеканоатом у кормицина А, и цис-3-гидрокси-5-додеценоатом у кормицина
Б (рис 10). Проявляют сходную с кормицином бактерицидную активность и
повреждают листья табака (Scaloni et al., 1998).

Рисунок 10. Структурная формула
корпептина А (Scaloni et al., 1998).
2.
Материалы и методы
2.1
Объекты исследования
В данной работе использовались штаммы, представленные в
таблице 5.
Таблица 5
Использованные в исследовании штаммы
|
Штамм
|
Источник
выделения
|
|
10864
|
Новая Зеландия,
1990
|
|
9849
|
Новая Зеландия,
1991
|
|
DSM
7228
|
Германия, июль
2002
|
|
DAR
61730
|
Австралия,
февраль 1989
|
|
37.1
|
ЧУП
"Озерицкий-Агро", Смолевичского района, Минской области, 23.04.2009
|
|
3’м
|
КСУП
"Светлогорская овощная фабрика", Светлогорского района, Гомельской
области, апрель 2007
|
|
3.2
|
УКАП фирма
"Днепр", Могилёвского района, Могилёвской области, 11.04.2008
|
|
JMB
9069
|
Институт
микробиологии и вирусологии им.Д.К. Заболотного НАН Украины
|
2.2
Среды и растворы
1. Плотная питательная среда:
агар-агар - 15 г
питательный бульон - до 1000 мл
. Буфер для ПЦР (pH 8,8):
Трис-HCl - 650 ммоль
(NH4) 2SO4 - 166 ммоль
МgCl2 - Твин 20
H2O - До 10 мл
. Загрузочный буфер (pH 7,6):
Трис-HCl - 10 ммоль
бромфенол синий - 30 мл
ксилен цианола - 30 мл
глицерин - 0,6 мл
ЭДТА - 60 ммоль2O - до 1 мл
. TAE-буфер (pH 8,0):
трис-основание - 4,84 г
уксусная кислота (ледяная) - 1,142 мл
.5М ЭДТАNa2 (pH 8,0) - 0,2 мл
этидия бромид (10 мг/мл) - 50 мкл2O
дистиллированная - до 1000 мл
агароза - 0,8 г
ТАЕ буфер (pH 8,0) - до 100 мл
2.3
Методы исследования
1. Амплификация ДНК.
1) Ночные культуры исследуемых штаммов с 1,5% агаризированной
среды наконечником дозатора вносили в пробирки Эппендорф с 50 мкл
дистиллированной стерильной воды и встряхивали. Количество клеток оценивали
визуально по степени мутности суспензии.
) В пробирку Эппендорф добавляли реактивы.
Таблица 6
Реактивы для ПЦР
|
Порядок
внесения
|
Реактив
|
Вносимый объём
|
|
1
|
Вода
дистиллированная стерильная
|
100 мкл
|
|
2
|
10х буфер
|
18 мкл
|
|
3
|
Смесь праймеров
PC 1/1 и PC 1/2,2 пмоль/мкл, и PC 5/1
и PC 5/2, пмоль/мкл
|
18 мкл
|
|
4
|
Смесь
нуклеотидов
|
18мкл
|
|
5
|
Taq-полимераза
|
1 ед.
|
Общий объём смеси - 172 мкл.
) Полученную смесь реактивов разливали по 19 мкл в девять
пронумерованных пробирок Эппендорф, стоящих на льду. В первые восемь пробирок
вносили по 1 мкл соответствующих клеточных суспензий. Девятую пробирку оставляли
без матрицы, в качестве негативного контроля.
) Девять образцов амплифицировали по следующей программе:
. один цикл:
94ºC 5 мин;
.27 циклов:
94ºC 30 сек,
62ºC 30 сек,
72ºC 1 мин;
. один цикл:
72ºC 3 мин;
. Охлаждение до 4ºC.
Пробы хранились замороженными.
2. Электрофорез ДНК в агарозном геле.
1) Агарозный гель плавили на водяной бане.
) В электрофорезный аппарат устанавливали планшетку для
лунок, заливали раствором агарозы. После застывания агарозы гребёнку доставали.
Планшетку с готовыми лунками заливали буфером ТАЕ.
) К размороженным амплифицированным пробам добавляли 4 мкл
6-кратного загрузочного буфера. Вносили препараты в лунки.
) В десятую лунку добавляли ДНК-маркер, для определения
размеров фрагментов.
) Электрофорез проводили при напряжении 100В.
) Гель извлекали из аппарата и визуализировали в
ультрафиолетовом свете.
3.
Результаты исследований и их обсуждение
Целью данного исследования была оценка возможности
использования видоспецифичных праймеров для диагностики Ps. corrugata как возбудителя некроза
сердцевины томата. Использовались праймеры, разработанные методом ПЦР со
случайной амплификацией полиморфной ДНК. Образцы были подвергнуты амплификации
и электрофорезу.
Исследовались как выделенные из заражённых растений (37.1,
3’м и 3.2), так и коллекционные.
Результаты электрофореза представлены на рисунке 11.

Рисунок 11. Результаты электрофореза ДНК.1 - 10864; 2 - 9849;
3-DSM 7228; 4 - DAR 61730; 5 - 37.1; 6 - 3’м; 7 - 3.2; 8 - JMB 9069; 9 -
негативный контроль; 10 - ДНК-маркер.
Ожидаемый продукт 1100 п. н. был получен из препаратов
штаммов 10864, 9849, DSM 7228, 37.1, 3’м.
Штамм 3.2 предварительно определён как Ps. corrugate, однако точная видовая
принадлежность не установлена.
Коллекционные штаммы DAR 61730 и JMB 9069 характерного
продукта не дали по неизвестным причинам.
Выводы
. Амплификацию с праймерами PC 1/1, PC 1/2 и PC 5/1, PC 5/2 можно использовать
для видового определения бактерий Ps. corrugata.
2. Использованный тест не универсален, т.к. не все изучаемые
штаммы дали характерный для Ps. corrugata продукт амплификации.
Список
литературы
1. И.А.
Прищепа, В.В. Вабищевич. Основные бактериальные болезни огурца и томата
защищенного грунта. - Несвиж: Несвиж. укрупн. тип., 2008. - 52 с.
2. Anzai
Y., Kim H.,Park J., Wakabayashi H. and Oyaizu H. Phylogenetic affiliation of
the pseudomonads based on 16S rRNA sequence // Int J Syst Evol Microbiol. -
2000. - 50. p.1563-1589.
. Bella
P., Greco S., Polizzi G., Cirvilleri G. and Catara V. Soil fitness and
thermal sensitivity of Pseudomonas corrugata strains // Acta Hortic. (ISHS). -
2003. - 614. p.831-836.
. Basim
H., Basim E., Yilmaz S. and Ilkucan M. First report of pith necrosis of tomato
caused by Pseudomonas mediterranea in Turkey // Plant Pathology. - 2005. - 54,
p.240.
. Catara
V., Gardan L. and Lopez M. M. Phenotypic heterogenety of Pseudomonas corrugata
strains from southern Italy // Journal of Applied Microbiology - 1997. - 83.
p.576-586.
. Catara
V., Arnold D., Cirvilleri G. and Vivian A. Specific oligonucleotide
primers for the rapid identification and detection of the agent of tomato
pith necrosis, Pseudomonas corrugata, by PCR amplification: evidence for
two distinct genomic groups // European Journal of Plant Pathology. - 2000. -
106. p.753-762.
. Catara
V., Sutra L., Morineau A., Achouak W., Christen R. and Gardan L. Phenotypic and
genomic evidence for the revision of Pseudomonas corrugata and proposal of
Pseudomonas mediterranea sp. nov. // International Journal of Systematic and
Evolutionary Microbiology. - 2002. - 52. p.1749-1758.
. Catara
V. Pseudomonas corrugata: plant pathogen and/or biological resource? //
Molecular plant pathology. - 2007. - 8 (3), p.233-244.
. Emanuele
M. C., Scaloni A., Lavermicocca P., Jacobellis N. S., Camoni L., Di Giorgio D.,
Pucci P., Paci M., Segre A. and Ballio A. Corpeptins, new bioactive
lipodepsipeptides from cultures of Pseudomonas corrugata // FEBS Lett. - 1998.
- 433, p.317-320.
. Fett
W. F., Cescutti P., and Wijey C. Exopolysaccharides of the plant pathogens
Pseudomonas corrugata and Ps, flavescens and the saprophyte Ps. chlororaphis //
Journal of Applied Bacteriology. - 1996. - 81. p.181-187.
. Gravel
V., Martinez C., Antoun H., Tweddell R. J. Antagonist microorganisms with the
ability to control Phythium damping-off of tomato seeds in rockwoll //
Biocontrol Sci. - 2005. - 50. p.771-786.
. Guo
Y., Zheng H., Yang Y., Wang H. Characterization of Pseudomonas corrugata Strain
P94 Isolated from Soil in Beijing as a Potential Biocontrol Agent // Curr
Microbiol. - 2007. - 55. p.247-253.
. Licciardello
G., Bertani I., Steindler L., Bella P., Venturi V. & Catara V. Pseudomonas
corrugata contains a conserved N-acyl homoserine lactonequorumsensingsystem;
it's role in tomato pathogenicity and tobacco hypersensitivity response // FEMS
Microbiol. Ecol. - 2007. - 61, p.222-234.
. Moura,
M. L., Jacques, M. A., Brito, L. M., Mourão, I. M. and Duclos, J.
Tomato pith necrosis (TPN) caused by P. corrugata and P. mediterranea: severity
of damages and crop loss assessment // Acta Hort. (ISHS). - 2005. - 695.
p/365-372.
. Pandey
A., Palni L., Hebbar K. Suppression of damping-off in maize seedlings by
Pseudomonas corrugata // Microbiol Res. - 2001, - 156. p. 191-194.
. Siverio
F., Cambra M., Gorris M. T., Corzo J., and Lopez M. Lipopolysaccharides as
Determinants of Serologica Variability in Pseudomonas corrugata // American
Society for Microbiology. - 1993. - 59. p.1805-1812.